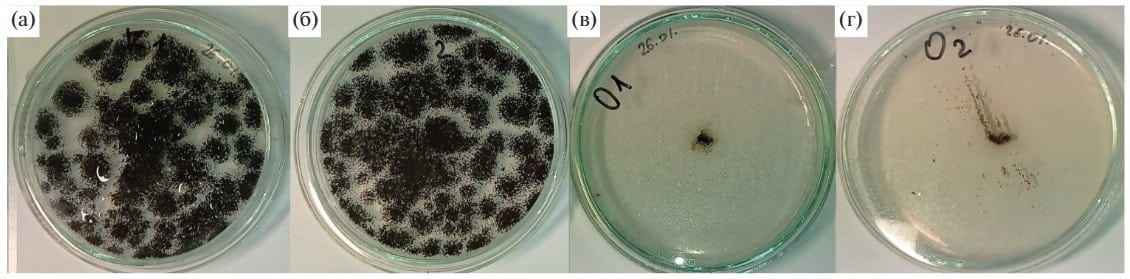
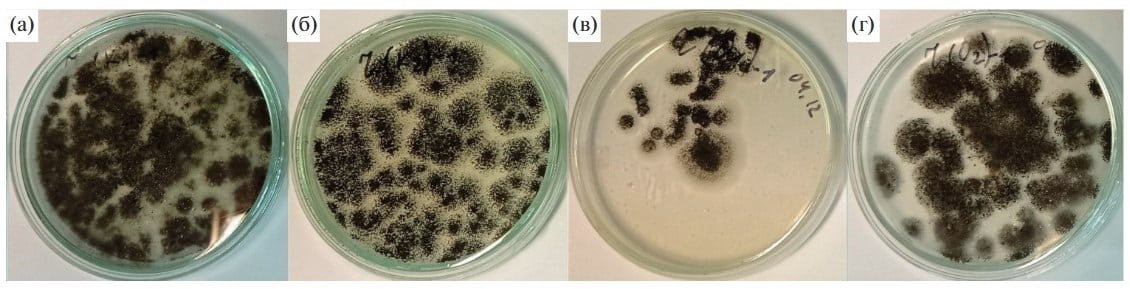

Уведомления
Авторизуйтесь или зарегистрируйтесь, чтобы оценивать материалы, создавать записи и писать комментарии.
Авторизуясь, вы соглашаетесь с правилами пользования сайтом и даете согласие на обработку персональных данных.
Российские ученые изучили, как черная плесень нейтрализует трибутилфосфат
Обычно, увидев черную плесень в помещении, мы стремимся избавиться от нее как можно скорее. Микроскопический гриб Aspergillus niger обладает уникальной живучестью и умением приспосабливаться к любым неблагоприятным условиям среды, но для человека воспринимается как признак бытовой неприятности. Он портит еду, размножается в сырых углах, вызывает аллергию и ассоциируется с антисанитарией. Однако именно эти качества — устойчивость к токсичным веществам и способность расти в экстремальных условиях — оказались ключевыми для неожиданной сферы его применения. Ученые задействовали этот гриб для утилизации одного из самых проблемных промышленных загрязнителей — трибутилфосфата.
Исследование опубликовано на английском языке в издании Biology Bulletin Reviews, на русском — в журнале «Микология и фитопатология».
Трибутилфосфат (ТБФ) — органическое соединение, представляющее собой эфир ортофосфорной кислоты и н-бутанола. Это вязкая, бесцветная, плохо растворимая в воде жидкость, обладающая высокой растворяющей способностью по отношению к ряду металлов и их соединений. Благодаря этим свойствам ТБФ нашел широкое применение как экстрагент при переработке отработанного ядерного топлива и выделении урана и плутония, в качестве компонента флотационных реагентов для разделения трудноотделимых металлов, таких как цирконий и гафний, а также при производстве пластификаторов, гербицидов, пеногасителей и гидравлических жидкостей.
Мировое производство ТБФ составляет десятки тысяч тонн в год, и следы этого соединения регулярно обнаруживаются не только в промышленных стоках, но и в почве, воздухе, воде, продуктах питания и даже в тканях человека — в том числе в плаценте.
ТБФ относится к классу органофосфатных соединений, известных своей высокой токсичностью. Он является специфическим ингибитором ферментов, включая ацетилхолинэстеразу, бутирилхолинэстеразу, липазы и протеазы. В результате нарушается передача нервных импульсов и работа мышц, что может привести к резкому снижению двигательной активности, параличу дыхания и даже гибели водных и наземных организмов.
Кроме того, ТБФ — липофильное соединение, то есть легко проникает через биологические мембраны и накапливается в тканях живых организмов, особенно в жировой ткани и печени. Уже при низких концентрациях он вызывает гибель водных микроорганизмов, рачков и рыб. В экспериментах, описанных в статье, среда с ТБФ даже при 50-кратном разбавлении убивала 25% инфузорий Paramecium caudatum за час, а при 8-кратном — 60% рачков Artemia salina.
Поэтому разработка эффективных, экологически безопасных методов его утилизации — одна из актуальных задач современной биотехнологии.

Предыдущие исследования показали, что два штамма Aspergillus niger (F-4815D и его «дочерний» вариант F-4816D) способны использовать в качестве источника фосфора, необходимого для жизни, даже такое ядовитое вещество как белый фосфор. Это навело группу ученых из Казанского национального исследовательского технологического университета, Казанского научного центра РАН, Института проблем промышленной экологии Севера Кольского научного центра РАН и Российского университета дружбы народов на мысль проверить способность этих плесневых грибов использовать для роста и органический фосфорсодержащий токсин — ТБФ.
В экспериментах грибы выращивали на среде Чапека с добавлением 0,01% ТБФ — как при наличии, так и при отсутствии неорганических фосфатов. Оба штамма выжили в присутствии ТБФ, а дочерний штамм F-4816D, полученный путем искусственного отбора, показал наиболее высокую устойчивость. В отсутствие других источников фосфора его рост даже усиливался в среде с ТБФ. Это позволяет предположить, что гриб расщепляет ТБФ на менее токсичные продукты — дибутилфосфат, монобутилфосфат, а затем — на неорганический фосфат и бутанол, которые использует в своем метаболизме.

То, что мы обычно считаем недостатком — упрямую способность плесени выживать в токсичных условиях, — стало ее главным достоинством. Благодаря этой устойчивости Aspergillus niger может колонизировать загрязненные зоны и выполнять функцию биологического детоксиканта.
Колонии Aspergillus niger F-4816D через 12 суток после посева: а — среда Чапека, б — среда Чапека + трибутилфосфат, в — среда Чапека без фосфатов, г — среда Чапека без фосфатов + трибутилфосфат / © «Микология и фитопатология»
Перспективы применения штамма F-4816D включают:
- создание биофильтриров и биореакторов с микроскопическими грибами для очистки промышленных сточных вод от ТБФ и связанных с ним металлов;
- рекультивацию почв на участках добычи и переработки руд.

Это особенно важно для регионов с развитой горнодобывающей или ядерной промышленностью, включая Мурманскую область, где присутствуют предприятия, работающие с редкими и радиоактивными металлами.
В разрыве протопланетного диска звезды WISPIT 2 ученые разглядели зарождающуюся планету. Это уже второй гигант в этом формирующемся «семействе», что делает его крайне похожим на молодую Солнечную систему.
Десятки странных архитектурных структур, обнаруженных в тропических лесах Юкатана, когда-то были не ритуальными сооружениями майя, а рынками с рядами прилавков, пришли к выводу археологи.
Жизнь в суровых условиях вечной мерзлоты — вызов даже для бактерий. Для нее требуются уникальные адаптации к холоду и другим стрессовым факторам. В новом исследовании ученые МФТИ с коллегами описали белки Exiguobacterium sibiricum — бактерии, найденной в многолетнемерзлых породах на северо-востоке Сибири. Исследователи выяснили, как набор белков в мембране микроба зависит от температуры, при которой его культивируют.
В парках некоторых стран все чаще можно заметить странную картину: синицы и воробьи вместо пуха и веточек приносят в клювах сигаретные окурки. Орнитологи из Польши решили выяснить, зачем птицы выстилают гнезда мусором, пропитанным никотином. Оказалось, пернатые нашли способ использовать вредную человеческую привычку для защиты своего потомства. Но, как это часто бывает в природе, у медали есть обратная сторона.
В разрыве протопланетного диска звезды WISPIT 2 ученые разглядели зарождающуюся планету. Это уже второй гигант в этом формирующемся «семействе», что делает его крайне похожим на молодую Солнечную систему.
Марсоход «Персеверанс» обнаружил в камнях на кромке кратера Езеро спектральные признаки минерала корунда, из которого на Земле образуются рубины и сапфиры. Такие спектры на Красной планете зарегистрировали впервые. Теперь ученые пытаются понять, при каких процессах он мог там сформироваться, ведь условия на Марсе заметно отличаются от тех, в которых корунд обычно образуется на Земле.
В парках некоторых стран все чаще можно заметить странную картину: синицы и воробьи вместо пуха и веточек приносят в клювах сигаретные окурки. Орнитологи из Польши решили выяснить, зачем птицы выстилают гнезда мусором, пропитанным никотином. Оказалось, пернатые нашли способ использовать вредную человеческую привычку для защиты своего потомства. Но, как это часто бывает в природе, у медали есть обратная сторона.
Марсоход «Персеверанс» обнаружил в камнях на кромке кратера Езеро спектральные признаки минерала корунда, из которого на Земле образуются рубины и сапфиры. Такие спектры на Красной планете зарегистрировали впервые. Теперь ученые пытаются понять, при каких процессах он мог там сформироваться, ведь условия на Марсе заметно отличаются от тех, в которых корунд обычно образуется на Земле.
За 10 лет лежания в почве сигаретные фильтры не растворились, а лишь замаскировались под грязь. Их пластиковые волокна распались на микрочастицы, намертво склеились с минералами и превратились во вторичный микропластик. Более того, на пятом году гниения мусор начал отравлять землю с новой силой.
Вы попытались написать запрещенную фразу или вас забанили за частые нарушения.
Понятно
Из-за нарушений правил сайта на ваш аккаунт были наложены ограничения. Если это ошибка, напишите нам.
Понятно
Наши фильтры обнаружили в ваших действиях признаки накрутки. Отдохните немного и вернитесь к нам позже.
Понятно
Мы скоро изучим заявку и свяжемся с Вами по указанной почте в случае положительного исхода. Спасибо за интерес к проекту.
Понятно
